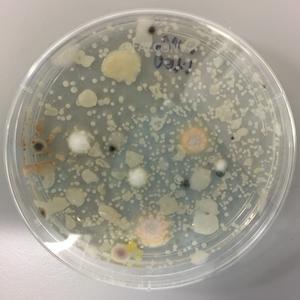

In the sixth episode of the Microbiology Lab Pod, recorded on December 17, the crew (Johan Bengtsson-Palme, Emil Burman, Haveela Kunche, Anna Abramova, Marcus Wenne, Sebastian Wettersten and Mahbuba Lubna Akter) talks about Haveela’s master thesis, virtual conferences and bring three Christmas themed papers. The specific papers discussed in the pod (with approximate timings) are as […]